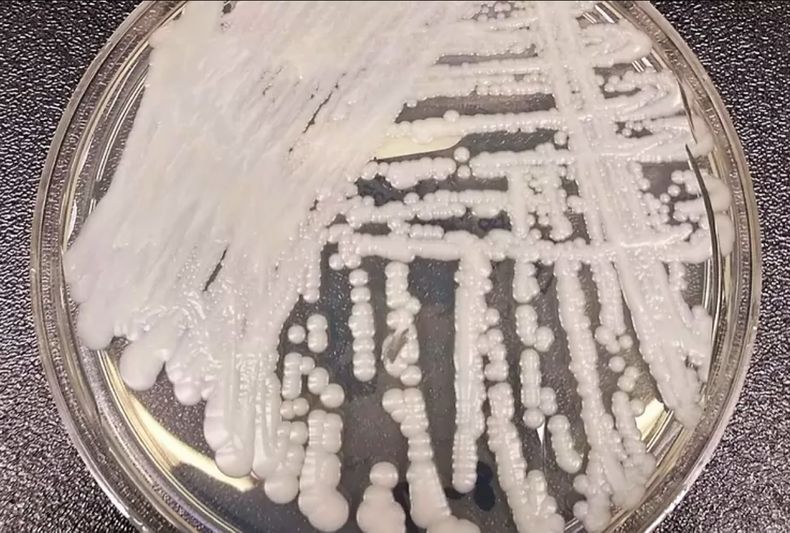
Candida Auris.jpg

La alerta se dio en el 2019 cuando un estudio respondió al misterio de por qué se habían originado casos simultáneos en distintas partes del mundo, de infección con una nueva superbacteria mortal y resistente a tratamientos: el cambio climático estaba detrás de este suceso.
Se trata del hongo Cándida Auris, que cuatro años después se está propagando a un ritmo alarmante entre pacientes de los hospitales de Estados Unidos, generando una alerta de salud pública que podría extenderse a otras partes del mundo.
¿Qué tiene que ver el cambio climático?
La temperatura es uno de los mecanismos que tiene el cuerpo para defenderse ante enfermedades. Las infecciones por hongos son raras en humanos porque estos no pueden crecer a temperaturas tan cálidas como las del cuerpo humano.
Pero el calentamiento global está aumentando la temperatura normal del ambiente, y podría propiciar que los hongos se adapten para sobrevivir a temperaturas mayores, soportando entonces las temperaturas del cuerpo y logrando propagarse en él.
Se trata de una más de las advertencias sobre cómo el cambio climático no sólo afecta la salud global por la exposición de las personas al clima extremo, sino por la alteración en cómo las enfermedades se transmiten y mutan.
¿Qué síntomas tiene?
Los síntomas de la infección por Cándida Auris varían según el tipo de infección y suelen camuflarse detrás de otras enfermedades ya que se suele propagar en hospitales donde las personas ya presentan otras afecciones.
Por esto, la única forma real de identificar la infección es a través de un examen. El virus puede colonizar el organismo de personas sin generar infección, y estas pueden propagar el hongo aunque no presenten síntomas.
Se puede propagar por contacto entre personas o con el equipamiento médico, y algunas cepas están mostrando resistencia ante los tratamientos antimicóticos más utilizados.